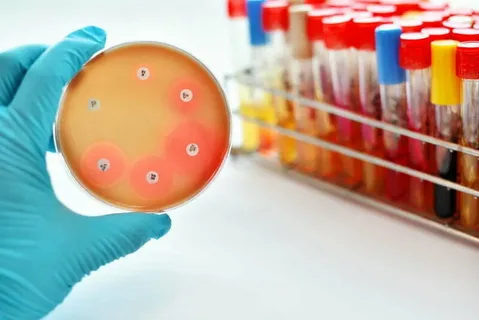
Antibiotic Susceptibility Testing Market

The antibiotic susceptibility testing market size brought approximately US$ 2.82 billion in sales in 2021. The global market is expected to reach a valuation of US$ 4.05 billion by 2028, growing at a compound yearly growth rate of 5.2%.
The Antibiotic Susceptibility Testing Market is witnessing significant growth attributed to several key factors driving its expansion. With the rise of antimicrobial resistance posing a global health threat, the demand for accurate and timely antibiotic susceptibility testing solutions has surged. Healthcare facilities, including hospitals and diagnostic laboratories, are increasingly relying on these tests to guide effective treatment decisions and combat antibiotic-resistant infections.
Technological advancements have played a pivotal role in enhancing the precision and efficiency of antibiotic susceptibility testing methods. Innovations such as automated systems, molecular techniques, and rapid diagnostic tests have revolutionized the field, enabling quicker identification of pathogens and determination of their susceptibility to antibiotics. This accelerated turnaround time is crucial for implementing targeted therapy and preventing the spread of resistant strains.
•Infectious diseases, prevailing at a high pace
•Increasing rate and tenure of hospitalization
•Growing significance of early diagnostics
•Soaring research interests in microbial susceptibility testing
•Improving funding scenario for research, driven by governments & private bodies
Growing use of antibiotics in treating even the most common health conditions remains a strong factor boosting demand for antibiotic susceptibility testing (AST).
Get a Sample Copy of the Report:
https://www.futuremarketinsights.com/reports/sample/rep-gb-8574
Increasing government funds for microbial and antibiotic susceptibility testing research and consistently improving outcome of PPPs in terms of enhanced screening and evaluation of antibiotics are playing a pivotal role in strengthening the performance of antibiotic susceptibility testing market.
CDC’s ‘AMR Challenge’ involving bioMérieux is a recently announced as objective to accelerate research efforts in the field of microbial resistance.
Research in Screening of High Pathogen
Concentration Samples to Propel Demand for AST
The process of spotting a specific set of genes responsible for antibiotic resistance is highly complicated when it comes to handling the complexities associated with samples that have high concentration of pathogens.
Some of the highly desirable antibiotic susceptibility testing systems that allow direct-from-sample pathogen identification through high pathogen concentration samples, are thus likely to gain high traction in coming years.
Growing research efforts in the recognition of the presence of a specific set of antibiotic resistant genes can direct efforts for identification and selection of narrow-spectrum antibiotics, which remains among the most prominent factors pushing installed base of such antibiotic susceptibility testing equipment.
A few recent launches in this segment include Genmark Diagnostics’ ePLEX Blood Culture ID Panel, Biomerieux’s BioFire FilmArray, and Luminex Corp.’s Verigene Bloodstream Infection Panel.
The report also sheds light on the increasing role of Ecommerce in the market by boosting the availability of antibiotic susceptibility testing systems. Offering improved access to susceptibility testing devices by industry’s leading brands, online retail operators have been attracting prominent vendors in the global antibiotic susceptibility testing market.
A number of vendors dealing in antibiotic susceptibility testing equipment are opting for devices that are available online owing to the significantly reduced costs and additional discounts on price.
Entry of Technologically Advanced AST Systems to Favor Market Growth
As indicated by research, the sales of antibiotic susceptibility testing equipment will witness healthy growth owing to increasing demand for specific susceptibility testing systems to define the scope of targeted therapy.
Targeting key pathogens is imperative to design a highly specific plan of treatment for a particular patient, and antibiotic susceptibility testing systems efficiently allow researchers to achieve it within a significantly short timeline.
With FDA approving a considerable number of antibiotic and microbial susceptibility testing equipment, especially in the recent past, FMI forecasts an impressive installed base for antibiotic susceptibility testing systems in coming years.
Advanced technology enabled antibiotic susceptibility testing equipment allows early diagnosis that in turn improves chances of developing targeted therapy earlier. One such recent advancement enjoying visibly growing traction in market includes oCelloScope.
This antibiotic susceptibility testing equipment by BioSense Solutions is an optical susceptibility screening system with the capability to deliver real-time, time-lapse imaging of multiple microbial combinations, simultaneously.
Recently, Thermo Fisher Scientific, Inc. and Becton, Dickinson and Company received FDA approvals for their new launches in antibiotic susceptibility testing space. Moreover, FDA passed an approval to a susceptibility testing device by bioMérieux that has an expanded capability to identify a particular pathogen.
Request Report Methodology:https://www.futuremarketinsights.com/request-report-methodology/rep-gb-8574
Key Segmentation:
Antibiotic Susceptibility Testing Market by Product:
•Instruments
oAutomated Broth Microdilution Systems
oManual Broth Microdilution Systems
oSemi-automated Broth Microdilution Systems
•Software & Services
oImage & Analysis Software
oInstallation Services
•Kits & Reagents
Antibiotic Susceptibility Testing Market by Application:
•Sepsis
•Respiratory Infections
•Gastrointestinal Infections
•Meningitis & Encephalitis
•Endocarditis
•Others
Antibiotic Susceptibility Testing Market by End User:
•Diagnostic Laboratories
•Hospitals
•Research Laboratories
Antibiotic Susceptibility Testing Market by Region:
•North America Antibiotic Susceptibility Testing Market
•Latin America Antibiotic Susceptibility Testing Market
•Europe Antibiotic Susceptibility Testing Market
•East Asia Antibiotic Susceptibility Testing Market
•South Asia & Pacific Antibiotic Susceptibility Testing Market
•Middle East & Africa (MEA) Antibiotic Susceptibility Testing Market
Author By:
Sabyasachi Ghosh (Associate Vice President at Future Market Insights, Inc.) holds over 12 years of experience in the Healthcare, Medical Devices, and Pharmaceutical industries. His curious and analytical nature helped him shape his career as a researcher.
Identifying key challenges faced by clients and devising robust, hypothesis-based solutions to empower them with strategic decision-making capabilities come naturally to him. His primary expertise lies in areas such as Market Entry and Expansion Strategy, Feasibility Studies, Competitive Intelligence, and Strategic Transformation.
Holding a degree in Microbiology, Sabyasachi has authored numerous publications and has been cited in journals, including The Journal of mHealth, ITN Online, and Spinal Surgery News.
About Future Market Insights (FMI)
Future Market Insights, Inc. (ESOMAR certified, recipient of the Stevie Award, and a member of the Greater New York Chamber of Commerce) offers profound insights into the driving factors that are boosting demand in the market. FMI stands as the leading global provider of market intelligence, advisory services, consulting, and events for the Packaging, Food and Beverage, Consumer Technology, Healthcare, Industrial, and Chemicals markets. With a vast team of over 5000 analysts worldwide, FMI provides global, regional, and local expertise on diverse domains and industry trends across more than 110 countries.
Contact Us:
Future Market Insights Inc.
Christiana Corporate, 200 Continental Drive,
Suite 401, Newark, Delaware – 19713, USA
T: +1-845-579-5705
For Sales Enquiries: sales@futuremarketinsights.com
Website: https://www.futuremarketinsights.com
LinkedIn| Twitter| Blogs | YouTube